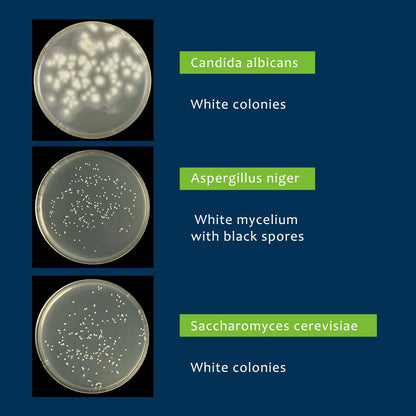
Potato Dextrose Agar (PDA) Plates – 10 Pre Poured Petri Dishes for Mushroom Cultivation & Science Projects

Potato Dextrose Agar (PDA) Plates – 10 Pre Poured Petri Dishes for Mushroom Cultivation & Science Projects
Potato Dextrose Agar (PDA) Plates – 10 Pre Poured Petri Dishes for Mushroom Cultivation & Science Projects
Worldwide Delivery Within 10 Days After Shipment
Ready-to-Use Agar Plates
Pre-poured Potato Dextrose Agar (PDA) plates come with nutrient-rich media, so you can start experiments immediately—no preparation needed.
Versatile Applications
Perfect for mushroom cultivation, mold detection, food testing, air quality monitoring, and cosmetic experiments.
Educational & Scientific Use
Ideal for classrooms, science fairs, and biology projects, promoting hands-on learning and experimentation.
Easy Home Testing
Whether a professional or hobbyist, these plates are simple to handle and deliver reliable, accurate results.
Durable & Safe
Triple-layer sealed packaging ensures safe transport. Robust and user-friendly for various applications, with warranty support if damaged during shipping.
Share
Shop On Amazon
Shipping & Return
Ships in 48h. 30-day returns for quality issues
Safe Payment
Pay with the world's most popular and secure payment methods
Shop with Confidence
Our Buyer Protection covers your purchase from click to delivery.
Trusted Support
24h response to all inquiries